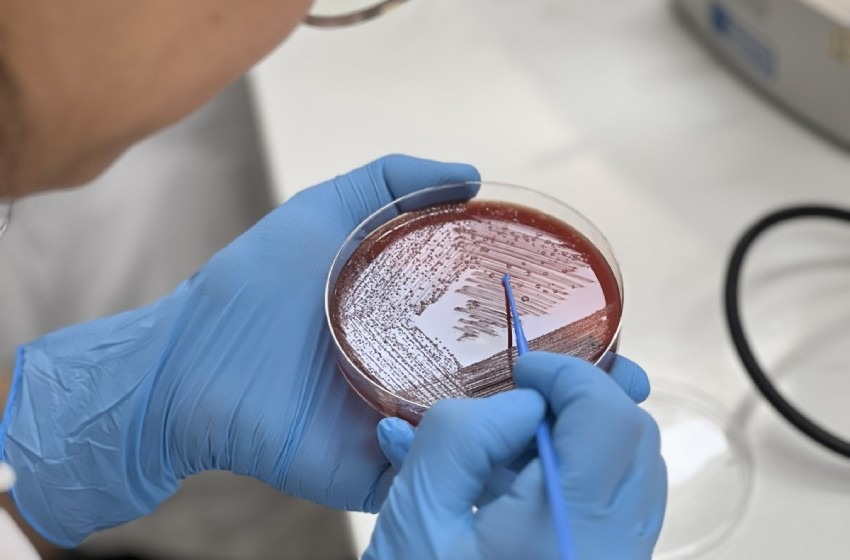

Tecnología Médica y BD Chile capacitaron a profesionales de campos clínicos en diagnóstico de bacterias anaerobias
El curso teórico-práctico, apoyado por Becton Dickinson Chile, reunió a 47 profesionales del área de microbiología de hospitales públicos, clínicas privadas y campos clínicos de las regiones Metropolitana y de O’Higgins.
En el campus Huechuraba de la Universidad Mayor se desarrolló el curso teórico-práctico Diagnóstico de anaerobios de importancia clínica, iniciativa académica orientada a fortalecer las capacidades diagnósticas en microbiología clínica, con especial énfasis en un grupo de bacterias asociado a infecciones de alta morbimortalidad.
La actividad fue organizada por la Escuela de Tecnología Médica y contó con el apoyo de la empresa Becton Dickinson Chile (BD). En total se capacitaron 47 profesionales del diagnóstico microbiológico, en su mayoría tecnólogos médicos provenientes de hospitales públicos, clínicas privadas y campos clínicos vinculados a la universidad.

El curso tuvo como expositores al Dr. Claudio Alburquenque, profesor titular de la Escuela de Tecnología Médica U. Mayor y al Dr. Arturo Levican, académico de la Universidad Católica de Valparaíso. El Dr. Alburquenque estuvo a cargo del módulo de diagnóstico por microbiología tradicional de bacterias anaerobias, que incluyó una clase teórica y dos jornadas de laboratorio práctico, mientras que el Dr. Levican dictó el curso sobre diagnóstico molecular e identificación por espectrofotometría de masa, en modalidad teórica.
Claudio Alburquenque explicó que el origen del curso responde a una necesidad detectada en el quehacer clínico. “Este curso nació como una inquietud de los profesionales que hacen diagnóstico microbiológico, porque poco se estudian los anaerobios. Son bacterias que crecen en ausencia de oxígeno y que causan infecciones que aumentan la morbimortalidad, especialmente en pacientes hospitalizados”, señaló.

El académico agregó que este tipo de bacterias está frecuentemente asociada a abscesos e infecciones derivadas de procedimientos clínicos o de la ruptura de barreras naturales del organismo. “En los laboratorios clínicos los anaerobios se dejan de lado, en parte porque su estudio es más engorroso y requiere condiciones especiales. Por eso es clave reforzar y actualizar permanentemente el diagnóstico anaerobio”, afirmó.
Por su parte Andrés Villagra, especialista clínico y de aplicaciones para microbiología de BD Chile y Bolivia, destacó la relevancia de la iniciativa para el sistema de salud. “En Chile y en gran parte de Latinoamérica, los anaerobios no se estudian ni se buscan de manera sistemática. Es fundamental identificar qué infecciones están causadas por estas bacterias para poder tratarlas adecuadamente y avanzar hacia una epidemiología nacional, porque hoy hay muy pocos datos locales”, indicó.

Villagra subrayó además el valor de realizar la capacitación en un entorno académico. “Que esta actividad se realice en una universidad le da una mayor relevancia formativa. La calidad de los docentes y el enfoque teórico-práctico hacen que sea una experiencia muy enriquecedora para los participantes”, sostuvo, añadiendo que el curso contempla certificación con evaluación y horas académicas.
Entre los asistentes se contó con profesionales de los hospitales Félix Bulnes, Sótero del Río, Barros Luco, San Juan de Dios, San Borja Arriarán, Lucio Córdova, Padre Hurtado, Exequiel González Cortés, La Florida, Hospital FACH, además de Red Salud, Clínica Alemana, consorcio BUPA y establecimientos de la región de O’Higgins como el Hospital de San Fernando y el Hospital Regional Rancagua.